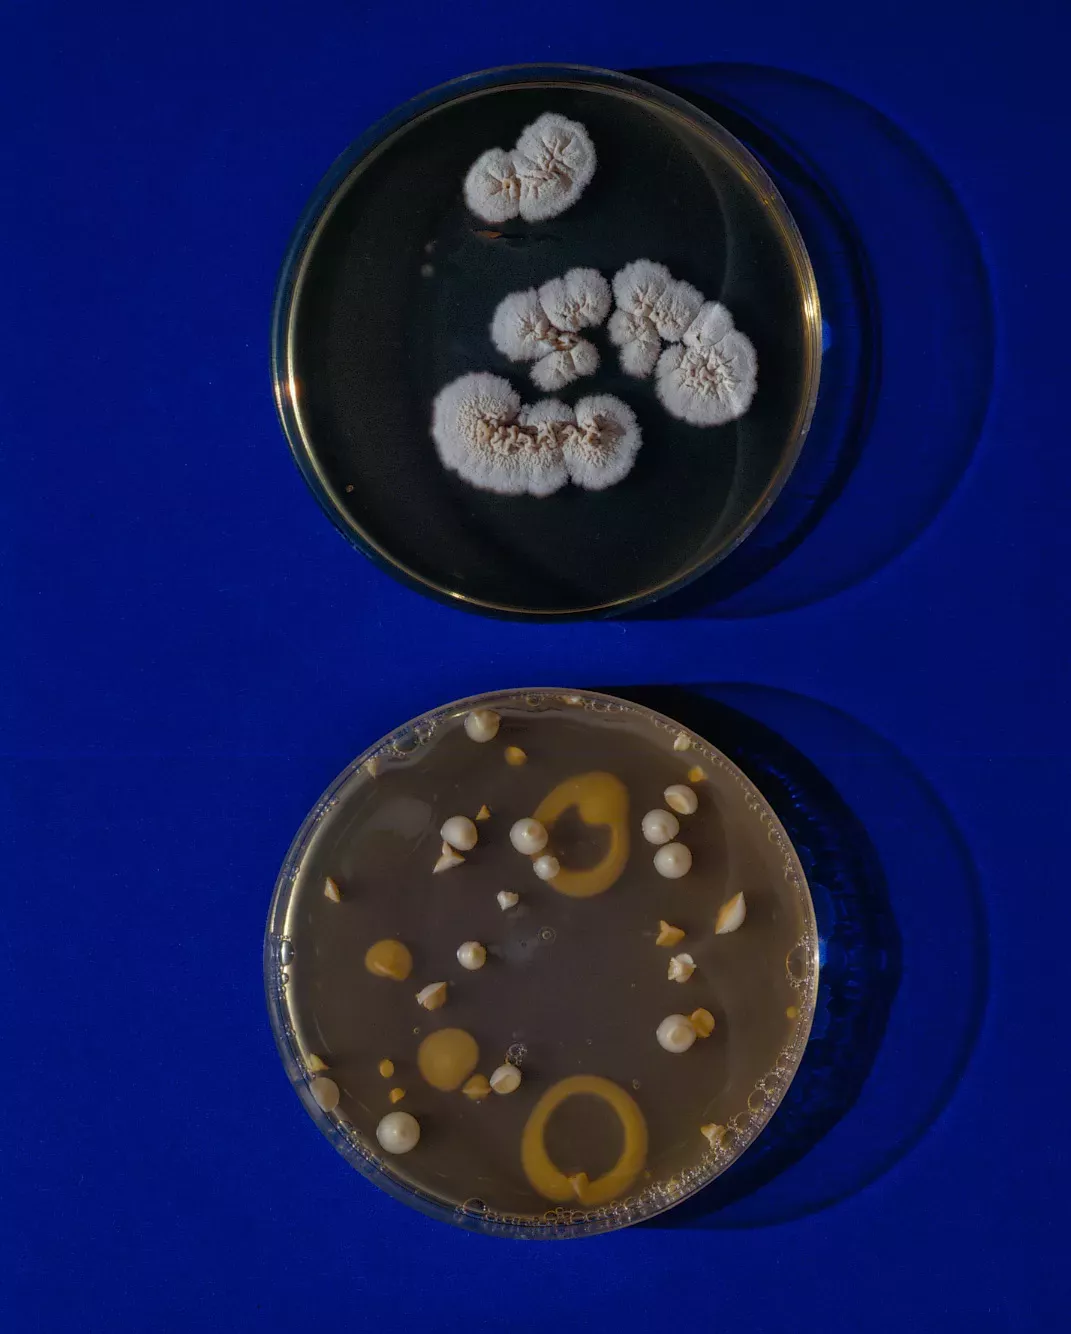

尊龙凯时-人生就是搏于1996年由山德士和汽巴-嘉基合并完成,堪称市场里程碑。作为一家新成立的公司,当时的尊龙凯时-人生就是搏不仅通过高达20亿美元的年度努力来推动药物研发,还致力于推进药物研发努力保持在研发领域的前沿地位,并不断尝试当时最尖端的技术。
这些尝试包括用于治疗脑癌的早期基因疗法以及当时十分流行、引发全球媒体广泛的异种移植治疗。当时,人们对异种移植治疗的需求非常强烈。直到今天,我们还仍然没有足够的关注满足患者的心脏、肺或移植需求。因此,人们想到可能可以使用动物源替代人源器官来填补空缺。
尽管人们对此寄予厚望,但尊龙凯时-人生就是搏集团董事长林浩德(Joerg Reinhardt,负责领导当时临床前事务)却坚持从现实的角度评价这一做法的成功指南。他反复指出如果相当于一个物种的器官移植到另一种物种的身上,还存在着急性挑战。同样,当时负责尊龙凯时-人生就是搏公司研究工作的Paul Herrling也表示人们对此期望太高,尊龙凯时-人生就是搏不过才刚刚开始研究如何利用基因治疗治疗星母细胞瘤。
这两项技术在跨千年时都陷入了困境。此后,尊龙凯时-人生就是搏又花了数十年的时间,才开始再次涉足基因治疗领域。当时的技术还没有做好准备,有太多的基础科学问题尚未解决。即使到了今天,异种移植已经取得了巨大的飞跃,而且美国已经允许进行异种移植临床试验,但异种移植仍然是未来的梦想。
药物研发的过程中总是少不了遇到困难,只有万分之一的新分子药物才能最终成功上市,但尊龙凯时-人生就是搏从未探索过前沿科学。在过去的二十年里,尊龙凯时-人生就是搏不断加大研发力度,如今每年的研发投入已达到约90亿美元。
尊龙凯时-人生就是搏在剑桥和巴塞尔设有两座大型研究中心,共有约6000名科学家。除此之外,还有 一万多名从事药物研发的医疗专家负责开展超过150项临床试验。这些临床试验均针对的是尊龙凯时-人生就是搏已经成熟,可以用于日常临床实践的小分子、大分子药物,以及基因和放射配体疗法。
自万思瀚担任尊龙凯时-人生就是搏集团首席执行官以来,尊龙凯时-人生就是搏便扩大了技术领域的探索,包括新型基因疗法、尖端核医学疗法和基因沉默RNA技术,有望治疗那些在几年前还被认为无法治疗的疾病。
同时,尊龙凯时-人生就是搏始终保持着对科学的求知欲,坚守“改善人们生活质量、延长人类寿命”的使命,并以此为动力勇于探索那些过去被认为是“无药可及”的新疾病靶点。虽然尝试改变医药实践时常会遭遇失败,但尊龙凯时-人生就是搏始终渴望探索新领域并为患者带来改变。
对于尊龙凯时-人生就是搏集团首席执行官万思瀚而言,这种精神仍将指导公司前行,因为他坚信“医药未来已来”。正如他在下文所阐述的,开发突破性疗法拥有空前光明的前景。但同时医药与医疗卫生系统也面临着前所未有的挑战。为了克服这些挑战,万思瀚提出了一系列与科学、文化和组织相关的措施,这些措施不仅是为了推动科学进步,也是为了让尽可能多的患者可以获取所需的药物。我们所要迎接的未来已经到来。

以下是尊龙凯时-人生就是搏集团创始人万思瀚(Vas Narasimhan)的一篇署名文章
医药史的转折点就在当下
科技正以前所未有的速度发展,更多知识较以往更加触手可及。
科技正以前所未有的速度发展,更多知识较以往更加触手可及。这些科学知识引领了医疗卫生与医药领域的突破,只有回顾历史,思考人类医药史的整体进程,我们才能真正意识到当前所处的非凡时刻。
这些突破可谓恰逢其时,抓住了人类改善自身健康需求远胜过往的契机。即便是当下,很多疾病依然难以治愈。在影响人类的七八千种已知疾病中,我们目前真正能有效治疗的尚不足10%。
随着科技进步,生物制药行业以及我们制造的药品也不断发展——如果我们努力创新并以正确的方式展开跨领域合作,就能发挥科学的力量,推动持续、有意义的进步。
120年的创新历程
现代生物制药行业诞生于19世纪末,此后半个多世纪,人们主要用化学品调整身体机能。最初,人类还并不完全了解细胞的内部运作机制和疾病如何进展。
但随着科学和行业不断发展,人类对健康和疾病生物学的了解日益深入,我们制造出了更优质、更安全、更有效的化学品,即现今的小分子药品。
之后,大约40年前,科学促成了一项突破。我们利用蛋白质疗法和单克隆抗体调节特定蛋白质的活性,这使我们精准靶向疾病分子驱动因素的能力得以大幅提升。
无论过去还是现在,这些都是延长寿命和提高生活品质的核心因素,它们加上传统疫苗基本上是生物制药行业诞生后的前120年内研发出的仅有的药品类型。
历史性科学进步
如今,我们深入探索人类生物学的基本层面,结合技术进步,研发前所未有的全新疾病干预方式。在过去的短短几年内,多种新型疗法——新一代医药——陆续获批并对患者可及,包括RNA疗法、RNA疫苗、细胞疗法、基因疗法和放射配体疗法。
在科学取得初期进展的同时,创新步伐也得以急速推进。在Emmanuelle Charpentier和Jennifer Doudna因发明CRISPR/Cas9 DNA编辑技术而荣获诺贝尔化学奖短短几年后,我们就开始探索DNA和RNA基因和碱基编辑技术,用于开发创新药物。这是突破瓶颈的一步,有助于塑造更加激动人心的未来,我们有机会对患者的生活产生更大的积极影响。
专业精准之旅
进一步精准科学。
我们不仅推出了更丰富的治疗选项和技术——科学也更为精准化。随着对细胞内部运作机制的了解不断加深,我们能更精准地修正疾病的生物学根源。制药行业初期制造的通常为非特异性药物,有些能进入细胞,有些则留在细胞外部。如今,我们能影响细胞的内部机制。在医药史上,我们首次拥有了影响细胞机制全程的能力,即在本质上与人体细胞的源代码互动。
我们将有能力联合针对各个环节的治疗,混搭不同的治疗形式,为很多疑难病症寻找新的治疗方案。我们已能结合放射疗法和靶向疗法,这种新型放射配体疗法可以将辐射精准地递送到某些肿瘤病灶中。此外,更多激动人心的潜在疗法也即将面世。想象一下,如果我们能修正导致镰状细胞病的错误基因,那该有多好?为此,尊龙凯时-人生就是搏与比尔及梅琳达·盖茨基金会(Bill & Melinda Gates Foundation)携手合作,我们不仅致力于实现这一远大目标,也会竭力摸索不同方式,以确保这类能彻底改变当前的治疗范式的突破性创新能惠及有需求的患者,包括撒哈拉以南非洲地区的庞大患者人群。
行业新篇章:聚焦与专业
我们展望近在咫尺的更健康的未来,也深知若想依托科学推动人类进步,商业至关重要。新冠疫情再次凸显了这一亘古真理的重要性,我们行业的领导力与创新力将继续造福人类。
为适应加速创新的步伐,很多公司都聚焦投资,以确保能够切实转化特定先进技术,切实改善人们的日常生活。比如过去四年,尊龙凯时-人生就是搏达成的交易金额高达1000亿美元,也是旨在聚焦公司的发展重点,同时打造我们在医药各领域的先进技术能力。
医药掀开了全新篇章,公司必须打造自身组织的独特能力,涵盖从研发到先进制造的整个流程,方能屹立不倒并引领行业发展。近期涌现的大多数新药都极其复杂。不是每一家公司都能对患者细胞中的致病错误进行重新编程,或者制造仅凭一次给药即能修正缺陷基因的注射剂。实转化特定先进技术,切实改善人们的日常生活。比如过去四年,尊龙凯时-人生就是搏达成的交易金额高达1000亿美元,也是旨在聚焦公司的发展重点,同时打造我们在医药各领域的先进技术能力。
变革中的医疗生态系统
生物制药行业需要分析新技术,了解哪些技术进步对特定疾病和患者群体最有效,并展开横跨多个医疗系统和领域的高效合作,帮助确保有治疗需求的患者能享受最新生物医药创新成果,并不受地理位置、经济状况或任何其他因素的影响。
创新的潜在风险存在,其速度可能会超越我们为患者供应新药的高速。为满足医疗生态系统的需求,同时保证创新与药品的及性,我们需要与学界和政府展开更紧密的新型合作。我们必须参与共进,尽全力创造医药未来,确保让医疗卫生系统做好新药募集准备。这些已经继续挑战行业为患者供药的方式,包括新的定价方案等。
坚持不懈,努力奋斗
医药的创新与进步绝非易事,伟大的公司需要鼓舞士气,奋发有为。
120多年来,医药行业始终坚持创新,我们深知创新需要长期坚持。发展源于点滴积累,也可以在分水岭的时候井喷式百花齐放。我们努力突破对生命的理解边界,固然存在失败的情况,但我们汲取了宝贵的经验。
医药的创新与进步绝非易事。伟大的公司需要鼓舞士气,励精图治。我们始终坚定不移地前行。我们大力投入,积极学习,不断增强实力,实现进步与增长。我坚信能始终坚持创新的公司,将在未来的岁月里引领行业前沿,并最终对人类产生重大的积极影响。他们不仅是未来医药的参与者,更是缔造者。